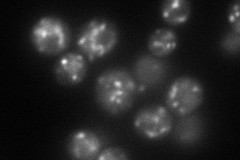
YLR083C
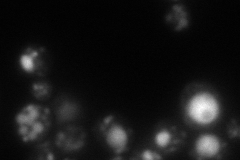
YLR083C
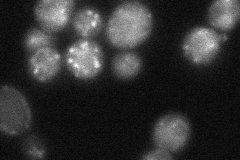
YLR083C
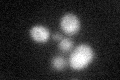
YLR083C

View description
Protein with a role in cellular adhesion and filamentous growth; similar to Tmn2p and Tmn3p; member of Transmembrane Nine family of proteins with 9 transmembrane segments; 24kDa cleavage product found in endosome-enriched membrane fractions
Localization:
Intensity:
Fold change:
Significance:
-
C’ GFP library in SD

cytosol21.92 -
N' NOP1pr-GFP in SD
punctate123.562 -
N' TEF2pr-mCherry in SD
punctate,vacuole61.6146 -
N' NATIVEpr-GFP in SD
punctate25.6313 -
N' TEF2pr-VC and Cyto-VN in SD

#N/A0 -
C’ GFP library in SD+DTT
cytosol16.890.77No -
C’ GFP library in SD+H2O2

cytosol19.220.87No -
C’ GFP library in Starvation Media

cytosol18.060.82No -
C’ GFP library on the background of Pup2-DaMP

cytosol -
C’ GFP library on the background of CCT mutant

cytosol16.86440.769221No
